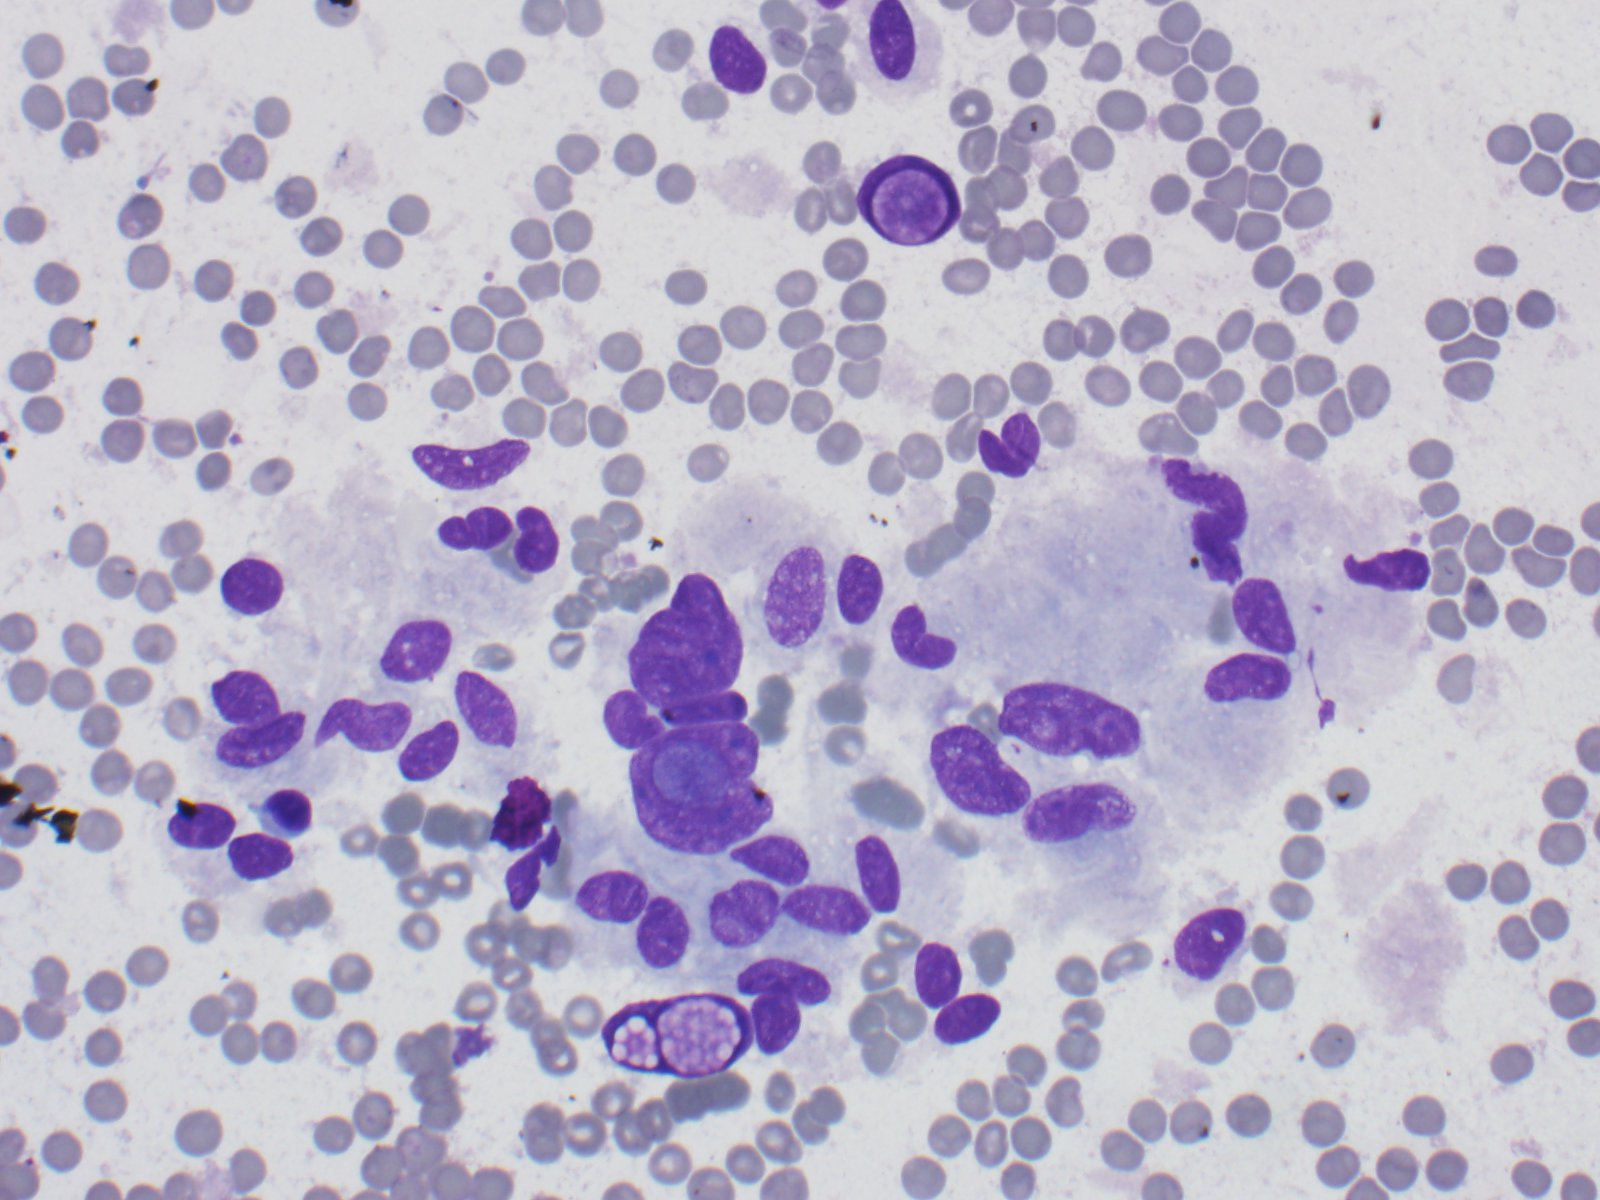
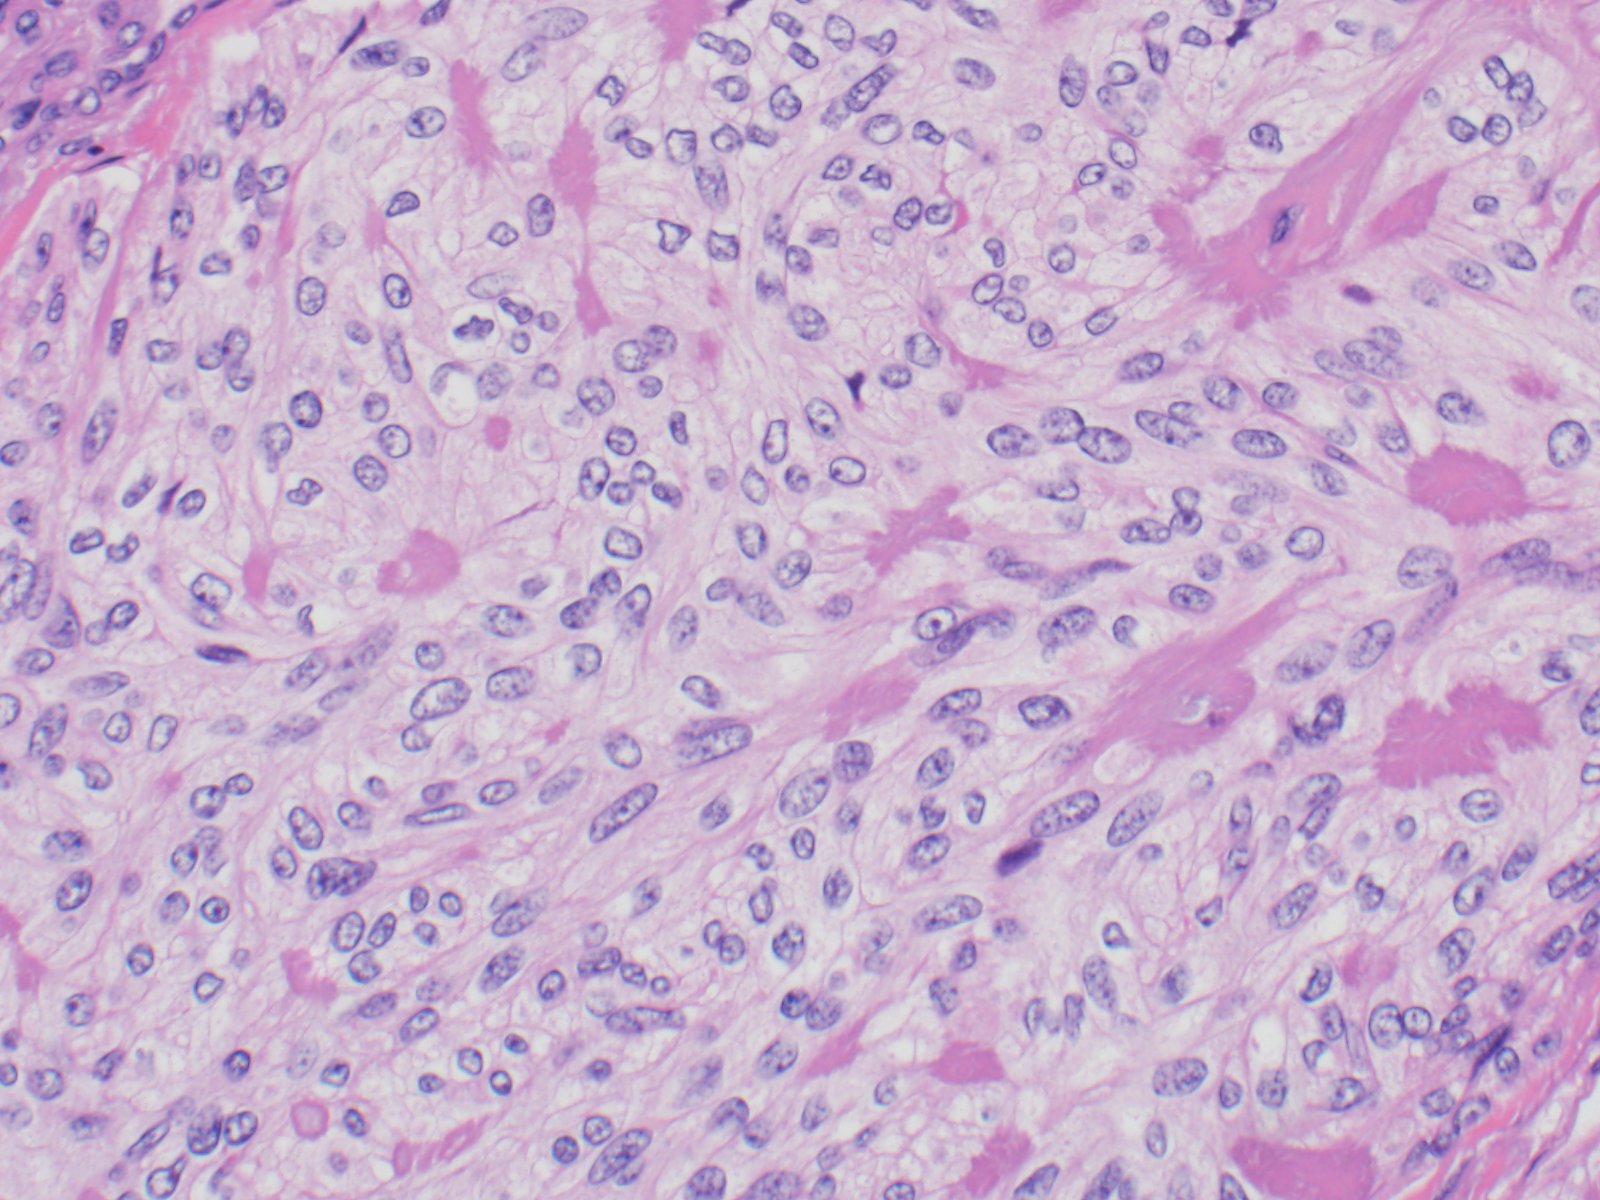

Case History:
A 40 y/o euthyroid female and a 3 cm left-sided thyroid nodule incidentally found.

What is the best diagnosis?
A. Papillary thyroid carcinoma
B. Medullary carcinoma
C. Paraganglioma
D. Hyalinizing trabecular tumor

Correct Answer: D. Hyalinizing trabecular tumor
Discussion:
The specimen consists of variably sized fragments of cells with elongated/spindled nuclei, intranuclear inclusions, moderate amounts of cytoplasm, and some eosinophilic amorphous material.
An original diagnosis of medullary carcinoma was rendered. There was insufficient material for cellblock, therefore the patient underwent serologic testing. Calcitonin and CEA levels were normal, which prompted a conversation with the endocrine surgeon to determine best course of treatment for the patient. An Afirma vial was available, and was sent for molecular analysis, which showed a PAX8/GLIS3 rearrangement. Taken together with the morphology, the serologic findings and the molecular result, the final diagnosis was hyalinizing trabecular tumor (in this case, mimicking medullary thyroid carcinoma). Lobectomy was subsequently performed, which confirmed the original cytologic diagnosis.
HTT of the thyroid is a rare follicular derived neoplasm that occurs more commonly in middle-aged euthyroid females, incidentally found. They have a characteristic rearrangement of GLIS and have a favorable prognosis. Cytologically, the cells resemble papillary thyroid carcinoma, medullary thyroid carcinoma and non-invasive follicular thyroid neoplasm with papillary-like nuclear features. On surgical pathology, HTT exhibits a prominent trabecular pattern, abundant intratrabecular hyalinized stroma and characteristic nuclear features of papillary carcinoma.
Case contributed by: Frida Rosenblum, M.D., Associate Professor, Anatomic Pathology